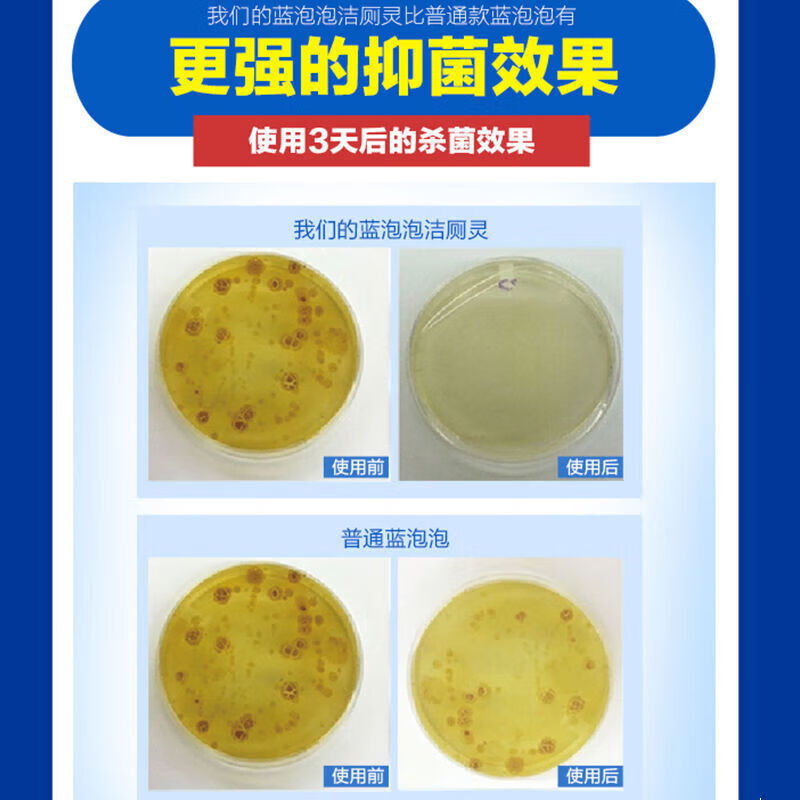
客笔鹿【精选直发】蓝泡泡洁厕灵洁厕宝香薰马桶水箱蹲坑清洁剂清香型家 蓝泡泡6瓶装

券后价¥25.8¥55.8省¥30.00
客笔鹿【精选直发】蓝泡泡洁厕灵洁厕宝香薰马桶水箱蹲坑清洁剂清香型家 蓝泡泡6瓶装
京东优惠券信息
满38减30元京东优惠券,此优惠券已领取44张,2026-01-02 ~ 2026-04-01
- 很多优惠券只能在手机端使用,领券后请在手机端或APP上查看券后价。
💰 安装京东优惠券查询工具Chrome插件,自动发现隐藏优惠券!立即安装
推荐说明
京东商城,品质无忧,万里挑一!
历史价格趋势
商品券后价25.8元,相当于原价优惠折扣4.6折,此时入手相当划算,快领券购买吧~
商品评价
商品怎么样,是否值得购买?好评率100%,0人评价。

猜你喜欢

水卫士强效洁厕灵洁厕液马桶清洁剂香氛洁厕泡泡盾防溅水防挂污除臭除菌 【实惠装】强效洁厕净500g*4瓶
券后价¥19.9原价¥29.9相当于折扣 6.7 折
券 满29减10
30天销量 6000
ONEFULL马桶魔法泡泡粉厕所清洁剂强力除垢去渍洁厕剂泡腾除臭去味留香 美鱼妈妈马桶魔法泡泡 240g 1个
券后价¥16.4原价¥23.4相当于折扣 7 折
券 满19减7
30天销量 18
ONEFULL蓝泡泡马桶水箱洁厕魔盒清洁剂强力除垢去黄厕所除臭去异味神器 250g 1盒
券后价¥16.55原价¥23.55相当于折扣 7 折
券 满19减7
30天销量 13
小林制药一滴消臭元卫生间厕所马桶除臭去异味芳香 【甜蜜玫瑰20ml】
券后价¥16.8原价¥21相当于折扣 8 折
券 满1减4.2
30天销量 12
狐狸爸爸欧洲进口洁厕灵马桶 强力去污除垢除异味尿碱养护釉面洁厕剂750ml 速效去重垢洁厕剂750ml*1
券后价¥29.9原价¥49.9相当于折扣 6 折
券 满49减20

雪润梦洁厕灵浴室清洁剂家用马桶洁厕剂除菌异味黄渍洁厕宝花香洁厕液 花香洁厕液*1瓶
券后价¥9.9原价¥12.9相当于折扣 7.7 折
券 满7减3